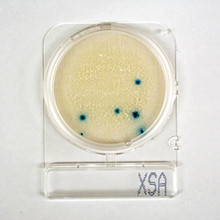
食品検査・食品分析

環境分析
地球規模で持続可能な社会の構築を考えてゆかなければならない時代の中で、企業にとっても、環境への取り組みは重要な経営課題のひとつとなっています。企業活動に対しては、さまざまな法律によって環境保全義務が課せられていますが、それらを遵守せずに環境を汚染した場合、法律によって罰せられるだけでなく、メディアなどを通じ広く世間に知られることによって、企業の信頼を失うことになりかねません。
- > 詳しくはこちら
建築物衛生管理
使用される延べ床面積が3,000㎡以上の建築物(特定建築物)には、「建築物における衛生的環境の確保に関する法律」(いわゆる「建築物衛生法」または「ビル管法」)によって、必要な衛生環境が定められています。(小・中学校などに関しては「学校保健安全法」が定められています)それらの環境を維持・管理していくためには、定期的な点検や整備、清掃や検査などが必要であり、計画的・効率的な実施導入が必須となります。
- > 詳しくはこちら
食品検査・食品分析
毎年全国で発生する集団食中毒は実に1,000件以上と言われていますが、細菌を原因とするものが半数以上を占め(55~60%)、その次にノロウイルスなどのウイルスを原因とするものと続きます。いずれにしても食中毒は食品を扱う企業にとっては大きな脅威となっています。一方、「食の安全性」をもとめる消費者の増加によって、企業としては取扱食品や加工製品に対する品質管理やトレーサビリティ管理など、これまで以上に厳しい対応が求められています。
- > 詳しくはこちら
スマート・フード・コミュニティ
発展途上国の経済成長や人口増加により、食料問題を地球規模で考えなければならない時代。自然に頼ってきたこれまでの食料生産に対し、その手法の多様化が求められています。近年注目を集めている植物工場など、完全環境制御型の食料生産手段=[食料工場]の実現は現代から将来における食料事情の不安を緩和する世界的ニーズに応えるものと言えます。また一方では、エネルギー生産の多様化も求められています。再生可能エネルギーの導入とその積極利用は、[食料工場]の効率的な運用とも密接にかかわってきています。
- > 詳しくはこちら